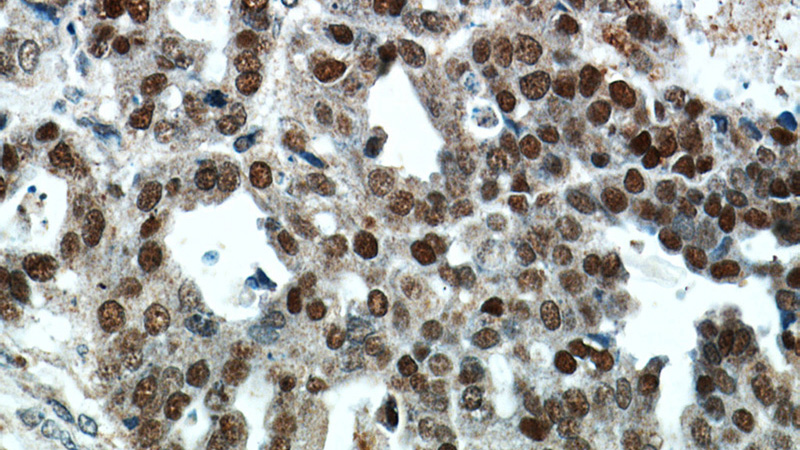
Immunohistochemical of paraffin-embedded human ovary tumor using Catalog No:116258(TP53 antibody) at dilution of 1:100 (under 40x lens)

-
Product Name
TP53 antibody
- Documents
-
Description
TP53 Rabbit Polyclonal antibody. Positive IP detected in A431 cells. Positive WB detected in A431 cells, HEK-293 cells, NIH/3T3 cells. Positive IHC detected in human ovary tumor tissue, human endometrial cancer tissue. Positive IF detected in HepG2 cells. Observed molecular weight by Western-blot: 53 kDa
-
Tested applications
ELISA, IHC, IP, WB, IF
-
Species reactivity
Human,Mouse,Rat; other species not tested.
-
Alternative names
Antigen NY CO 13 antibody; Cellular tumor antigen p53 antibody; FLJ92943 antibody; LFS1 antibody; P53 antibody; Phosphoprotein p53 antibody; TP53 antibody; TRP53 antibody; tumor protein p53 antibody; Tumor suppressor p53 antibody
-
Isotype
Rabbit IgG
-
Preparation
This antibody was obtained by immunization of TP53 recombinant protein (Accession Number: NM_001126112). Purification method: Antigen affinity purified.
-
Clonality
Polyclonal
-
Formulation
PBS with 0.02% sodium azide and 50% glycerol pH 7.3.
-
Storage instructions
Store at -20℃. DO NOT ALIQUOT
-
Applications
Recommended Dilution:
WB: 1:500-1:5000
IP: 1:500-1:5000
IHC: 1:20-1:200
IF: 1:20-1:200
-
Validations

WB result of p53 antibody (Catalog No:116258, 1:1000) with sh-control and sh-p53 transfected A431 cells.

A431 cells were subjected to SDS PAGE followed by western blot with Catalog No:116258(TP53 antibody) at dilution of 1:1000

Immunohistochemical of paraffin-embedded human ovary tumor using Catalog No:116258(TP53 antibody) at dilution of 1:100 (under 10x lens)
Immunohistochemical of paraffin-embedded human ovary tumor using Catalog No:116258(TP53 antibody) at dilution of 1:100 (under 40x lens)

IP Result of anti-TP53 (IP:Catalog No:116258, 3ug; Detection:Catalog No:116258 1:1000) with A431 cells lysate 1650ug.

Immunofluorescent analysis of HepG2 cells using Catalog No:116258(TP53 Antibody) at dilution of 1:50 and Alexa Fluor 488-congugated AffiniPure Goat Anti-Rabbit IgG(H+L)
-
Background
TP53, also named as P53 and NY-CO-13, belongs to the p53 family that functions as a central mediator for organizing cellresponses to various stress and anticancer drugswith apoptosis,G1- phase arrest, and DNA repair.[PMID: 20346922]. In addition, TP53 appears to induce apoptosis through nontranscriptional cytoplasmic processes. In unstressed cells, TP53 is kept inactive essentially through the actions of the ubiquitin ligase MDM2, which inhibits TP53 transcriptional activity and ubiquitinates TP53 to promote its degradation[PMID: 22330136]. TP53 acts as a tumor suppressor in many tumor types and induces growth arrest or apoptosis depending on the physiological circumstances and cell type. It is involved in cell cycle regulation as a trans-activator that acts to negatively regulate cell division by controlling a set of genes required for this process.
Related Products / Services
Please note: All products are "FOR RESEARCH USE ONLY AND ARE NOT INTENDED FOR DIAGNOSTIC OR THERAPEUTIC USE"
